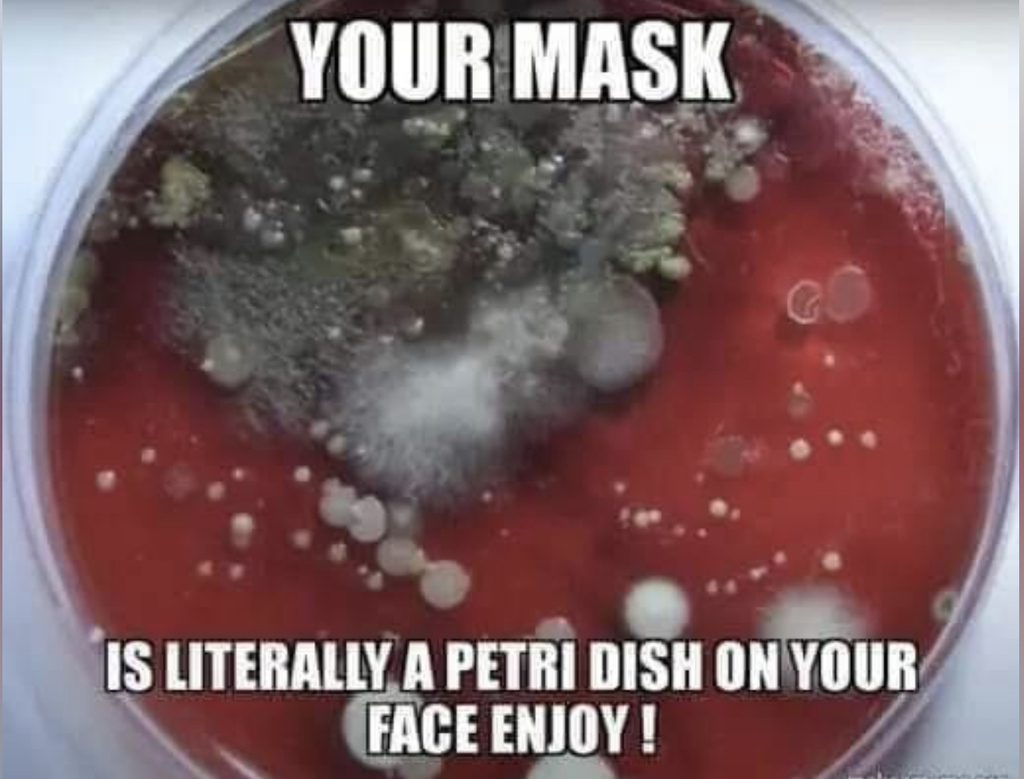
xlarge

Lakhota
Diamond Member
BREAKING: MAGA Rep. Matt Gaetz ignites a Republican civil war on the floor of Congress by calling to block all spending bills unless Hunter Biden is subpoenaed and President Biden is impeached on fake charges.
And he wasn't done there. This is truly insane — and nightmare news for Republicans...
Gaetz threatened that if his unhinged demands are not met, he and his far-right cronies will initiate a "motion to vacate the chair" which means removing Kevin McCarthy as Speaker of the House.
In essence, they intend to hold the government hostage to push through an investigation that will lead nowhere and an impeachment that has no foundation in reality.
Democrats control the Senate so there is no chance of Biden being removed from office. More importantly, there is no legitimate reason to impeach him. Republicans are relying on vague accusations of "corruption."
The American people will see that there is no evidence and no reason to impeach and will once again realize that Republicans are wasting time and money to score cheap political points.
This is going to backfire in spectacular fashion.

And he wasn't done there. This is truly insane — and nightmare news for Republicans...
Gaetz threatened that if his unhinged demands are not met, he and his far-right cronies will initiate a "motion to vacate the chair" which means removing Kevin McCarthy as Speaker of the House.
In essence, they intend to hold the government hostage to push through an investigation that will lead nowhere and an impeachment that has no foundation in reality.
Democrats control the Senate so there is no chance of Biden being removed from office. More importantly, there is no legitimate reason to impeach him. Republicans are relying on vague accusations of "corruption."
The American people will see that there is no evidence and no reason to impeach and will once again realize that Republicans are wasting time and money to score cheap political points.
This is going to backfire in spectacular fashion.